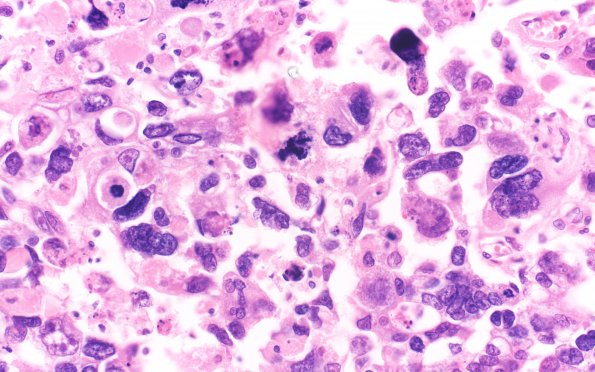
2A5 Choriocarcinoma, Pineal (Case 2) H&E 40X 1

Table of Contents
Washington University Experience | NEOPLASMS (NON-GLIAL NON-NEURONAL) | Germ Cell Neoplasm - Choriocarcinoma | 2A5 Choriocarcinoma, Pineal (Case 2) H&E 40X 1
Additional images showing both cytotrophoblasts and multinucleated syncytiotrophoblasts. (H&E)